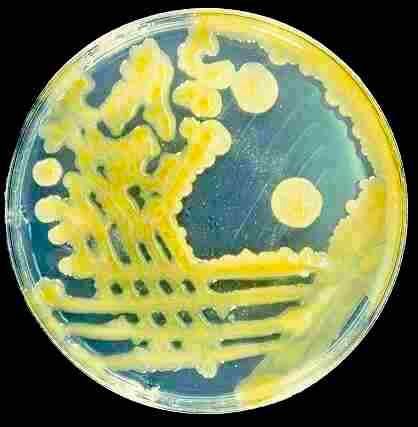

Our keynote @plantteaching.bsky.social about the importance of plants, from photosynthesis to evolution and development... through aliens! 🌱🛸
@johninnescentre.bsky.social @quadraminstitute.bsky.social @earlhaminst.bsky.social
#NBIAST2025




go.nature.com/4n1DTY7

go.nature.com/4n1DTY7





plantae.org/how-to-manag...

plantae.org/how-to-manag...
#theconferencetoendallconferences #TCTeAC
A plant breeding company reached out to see if my lab could rate their plant lines for their resistance to Ralstonia. I said "maybe, but these assays require personnel time and materials"

Cassava growers often see this: brown necrosis starting at the leaf edges and spreading inward.
What’s the most likely cause?
• Fungal pathogen
• Bacterial pathogen
• Viral pathogen
• Nematodes
Drop your diagnosis!
Answer revealed tomorrow.
#PlantDoctorQuiz #PlantHealth

Cassava growers often see this: brown necrosis starting at the leaf edges and spreading inward.
What’s the most likely cause?
• Fungal pathogen
• Bacterial pathogen
• Viral pathogen
• Nematodes
Drop your diagnosis!
Answer revealed tomorrow.
#PlantDoctorQuiz #PlantHealth
We analyzed 2,723 high-coverage whole genomes from Brazilians to explore how five centuries of colonization, forced migration, and admixture have shaped genetic diversity and impacted health.
📄 science.org/doi/10.1126/...
🧵👇

We analyzed 2,723 high-coverage whole genomes from Brazilians to explore how five centuries of colonization, forced migration, and admixture have shaped genetic diversity and impacted health.
📄 science.org/doi/10.1126/...
🧵👇
After a deep appreciation: OMG! How adorable fairies! 🧚♀️✨ My inner child so needed this today!

After a deep appreciation: OMG! How adorable fairies! 🧚♀️✨ My inner child so needed this today!



